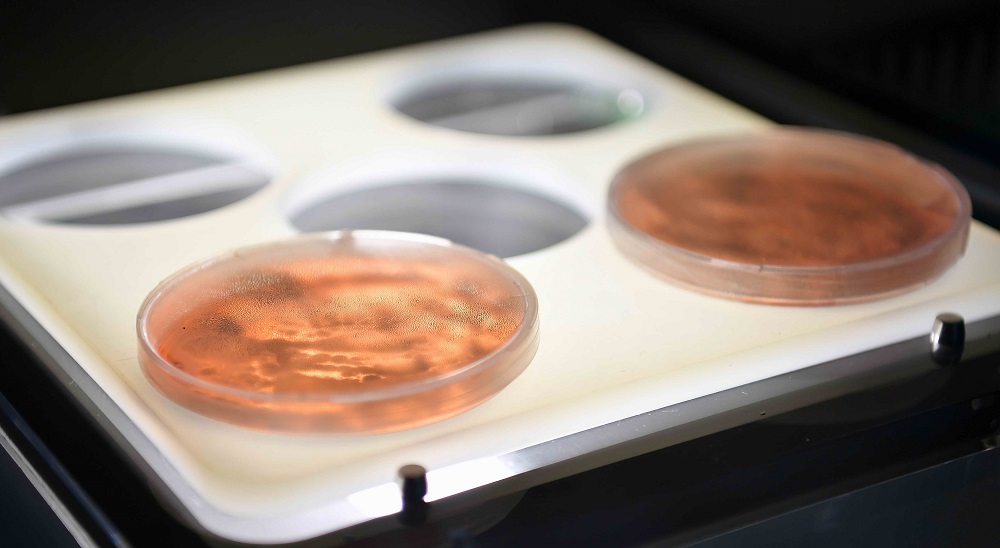

Свидетельство о постановке на учет, переучет периодического печатного издания, информационного агентства и сетевого издания №17614-ИА выдано 15.03.2019 Комитетом связи, информатизации и информации Министерства по инвестициям и развитию Республики Казахстан.
Свидетельство о постановке на учет отечественного телерадио канала №KZ23VJB00000123 выдано 08.09.2016 Комитетом связи, информатизации и информации Министерства по инвестициям и развитию Республики Казахстан.
Соглашение об использовании материалов